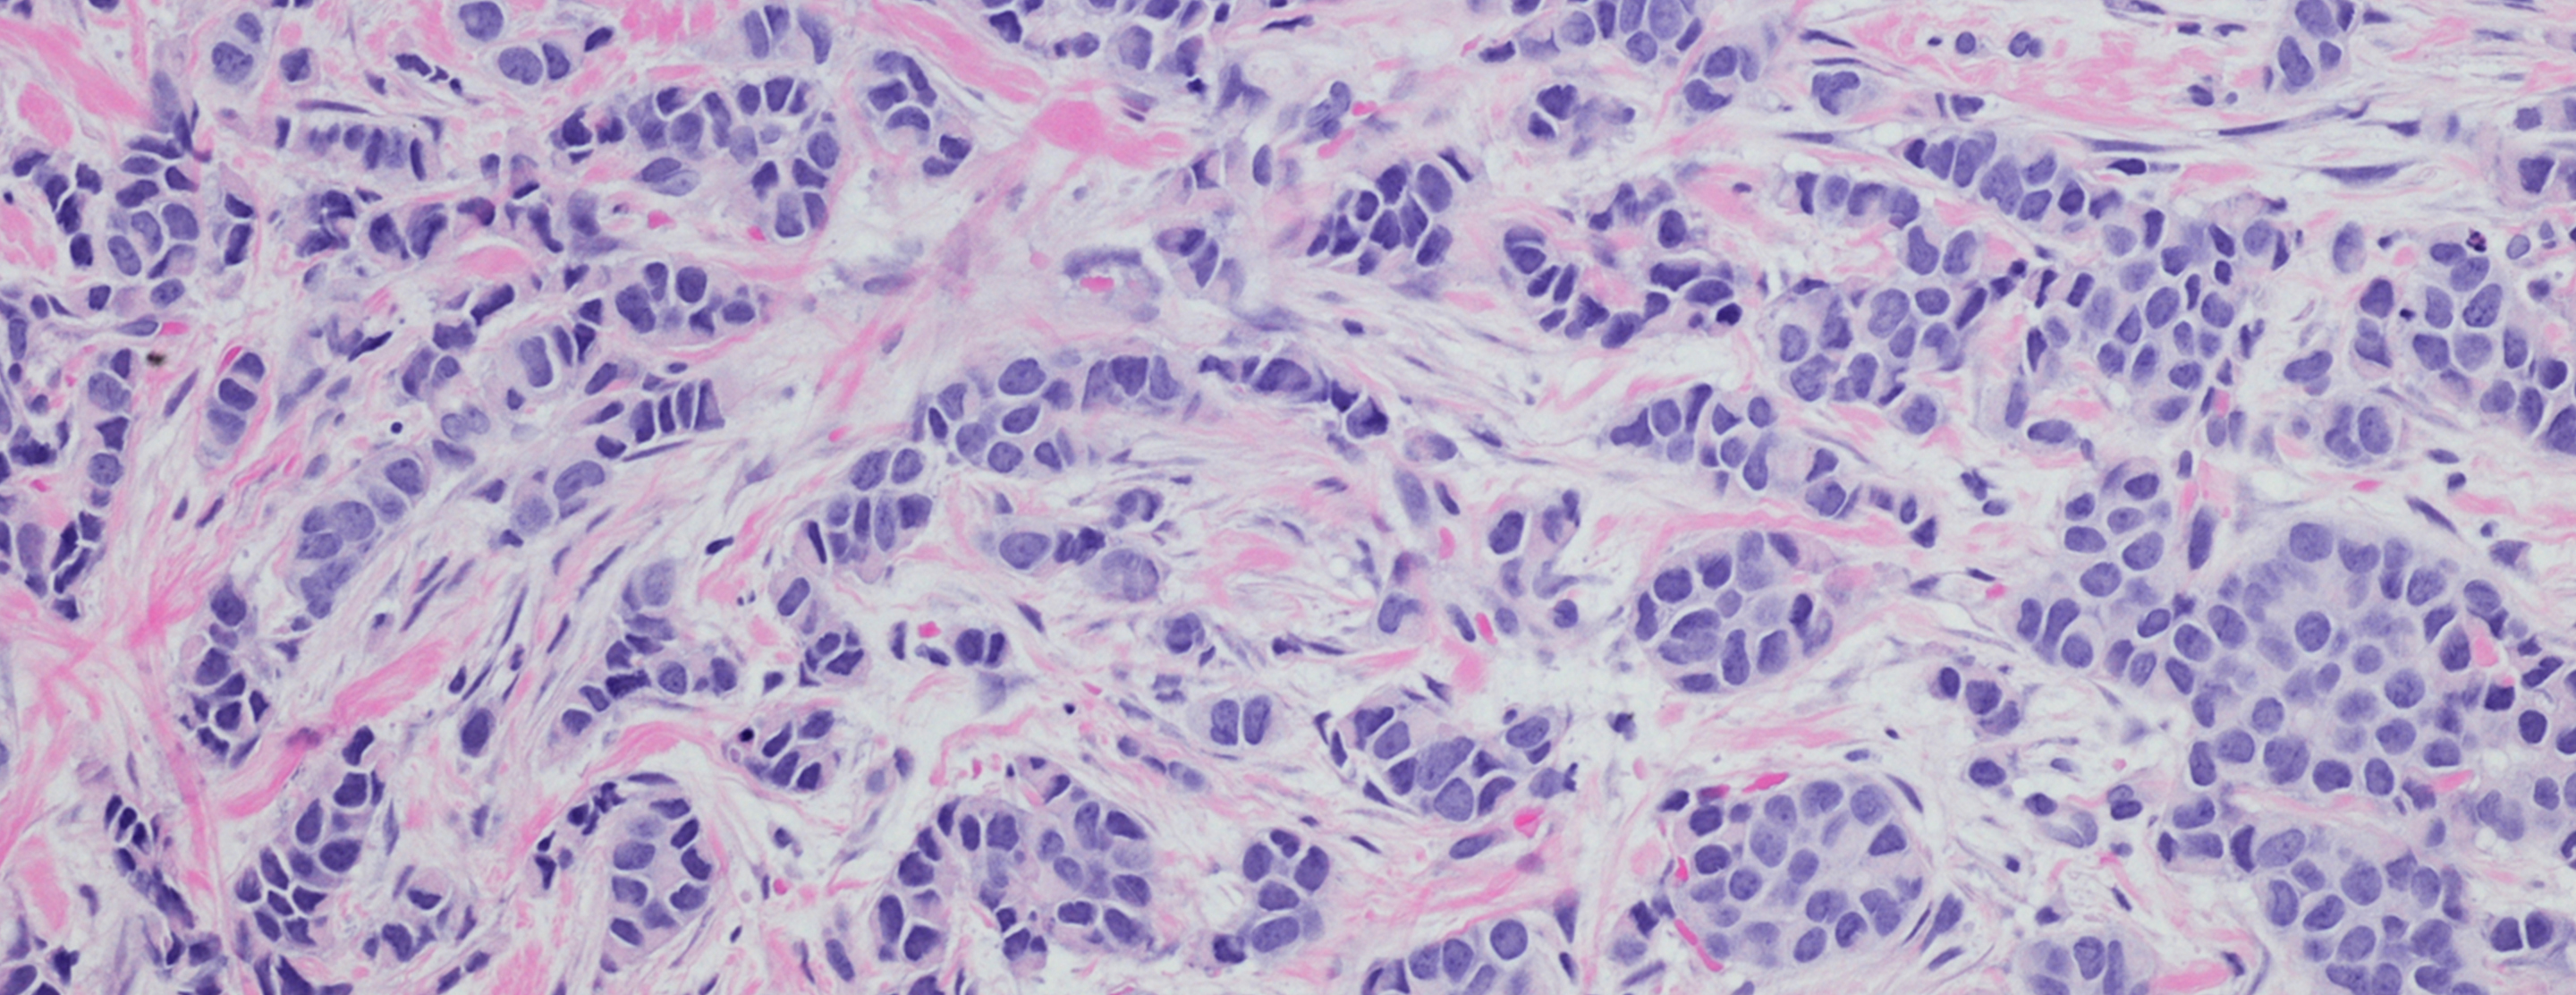

Basic Facts About Breast Health: Breast Cancer Staging
Stage 0
Very early breast cancer. This type of cancer has not spread within or outside the breast. It is sometimes called DCIS, LCIS or breast cancer in situ or noninvasive cancer.
Stage I
The cancer is no larger than about one inch in size and has not spread outside the breast.
Stage II
The doctor may find any of the following:
- The cancer is no larger than one inch, but has spread to the lymph nodes under the arm.
- The cancer is between one and two inches. It may or may not have spread to the lymph nodes under the arm.
- The cancer is larger than two inches, but has not spread to the lymph nodes under the arm.
Stage III
Stage III is divided into stages IIIA and IIIB:
Stage IIIA
- The cancer is smaller than two inches and has spread to the lymph nodes under the arm. The cancer also is spreading further to other lymph nodes.
- The cancer is larger than two inches and has spread to the lymph nodes under the arm.
Stage IIIB
The doctor may find either of the following:
- The cancer has spread to tissues near the breast, such as the skin and chest wall, including the ribs and the muscles in the chest.
- The cancer has spread to lymph nodes inside the chest wall along the breastbone.
Stage IV
The cancer has spread to other parts of the body, most often the bones, lungs, liver or brain. Or, the tumor has spread locally to the skin and lymph nodes inside the neck, near the collarbone.
Inflammatory Breast Cancer
Inflammatory breast cancer is a rare, but very serious, aggressive type of breast cancer. The breast may look red and feel warm. You may see ridges, welts or hives on your breast; or the skin may look wrinkled. It is sometimes misdiagnosed as a simple infection.
Recurrent Breast Cancer
Recurrent disease means that the cancer has come back (recurred) after it has been treated. It may come back in the breast, in the soft tissues of the chest (the chest wall) or in another part of the body.
Breast Cancer In Situ – DCIS and LCIS
Many breast cancers being found are very early cancers known as breast cancer in situ or noninvasive cancer. Most of the cancers are found by mammography. These very early cells changes may become invasive breast cancer. Two types of breast cancer in situ are:
- Ductal carcinoma in situ (DCIS), which means that abnormal cells are found only in the lining of a milk duct of the breast. These abnormal cells have not spread outside the duct. They have not spread within the breast, beyond the breast, to the lymph nodes under the arm or to other parts of the body.
There are several types of DCIS. If not removed, some types may change over time and become invasive cancers. Some may never become invasive cancers. DCIS is sometimes call intraductal carcinoma. - Lobular carcinoma in situ (LCIS), which means that abnormal cells are found in the lining of a milk lobule. Although LCIS is not considered to be actual breast cancer at this noninvasive stage, it is a warning sign of increased risk of developing invasive cancer.
LCIS is sometimes found when a biopsy is done for another lump or unusual change that is found on a mammogram.
Prognosis
Most women who are treated for early breast cancer go on to live healthy, active lives. You may have more choices of treatment if your breast cancer is found early.
Treatments have changed over time. Today, many women who are diagnosed with breast cancer do not have to lose a breast. Because there are improved ways to treat breast cancer, it is more important than ever for you to learn all you can. Working with your team of medical specialists, you can play a key role in choosing the treatment that is best for you.
Once your doctor has determined your specific type and stage of breast cancer, you can begin to plan for your treatment and recovery. Your chance of recovery will depend on many factors, including:
- The type and stage of your cancer. The kind of cancer, the size of the tumor and whether it is only in your breast or has spread to any lymph nodes or to other parts of your body.
- How fast the cancer is growing. Special tests on the tissue can measure how fast the cancer cells are dividing and how different they are compared to normal breast cells.
- How much the breast cancer cells depend on female hormones (estrogen and progesterone) for growth. This can be measured by hormone receptor tests. Patients whose tumors are found to be dependent on hormones (described as estrogen-positive or progesterone positive) can be treated with hormonal therapy to prevent further growth or recurrence of breast cancer.
- Your age and menopausal status.
- Your general state of health.
The material in the above sections is taken in its entirety from the National Cancer Institute Booklet (No. 98-4251) entitled, "Understanding Breast Cancer Treatment: A Guide for Patients."
Basic Facts About Breast Health:
UCSF Health medical specialists have reviewed this information. It is for educational purposes only and is not intended to replace the advice of your doctor or other health care provider. We encourage you to discuss any questions or concerns you may have with your provider.














